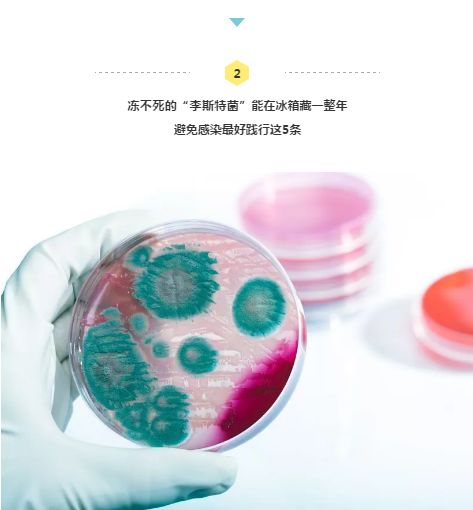
冰箱里的食物哪一些孕妇不可以吃,冰箱里不能加热的食物孕妇怎么吃

天气逐渐炎热,细菌易滋生。冰箱、厨房都成了重灾区。
最近杭州就有一位二胎妈妈因吃了冰箱里的食物,差点丢了自己和肚子里二宝的命……


当打开子宫抱出胎儿的一瞬间,医生们倒吸一口凉气——
子宫内的羊水浑浊发黄,而新生儿全身灰白、肌张力偏低,出生评分只有4分(满分10分),白细胞达到6万多(正常新生儿一般在2万以内),可能有严重的败血症……造成这一切的元凶正是被称为“冰箱杀手”的李斯特菌。

2016年7月,国家食药监总局就发布风险提示,李斯特菌已成威胁食品安全的重要因素,64%感染者家中冰箱有它身影。冰箱中的异味就是细菌的警示。
人体感染李斯特菌可导致脑膜炎、败血症等,甚至能造成孕妇死胎!它对孕妇、新生儿、老人*伤杀**力极强!
大多数免疫功能正常的人吃了被李斯特菌污染的食物只有轻微的流感样症状和胃肠道症状,很快就能自愈。但孕妇、新生儿、老人和免疫功能低下的人(如HIV患者)最容易感染李斯特菌。


李斯特菌堪称菌界小强!
它生存能力极强,耐冷、耐盐、耐酸、耐碱,在0℃~45℃都能快乐存活,甚至在-20℃的冷冻室也能存活1年!所以拥有“冰箱杀手”的外号。

除了冰箱,生活中的一些小习惯,也可能让食物充满细菌,从而诱发疾病甚至致命。比如——

“猝死菌”即肉毒杆菌,它产生的毒素即为肉毒素。
只需1g就可以毒死100万人,是名副其实的“天下第一毒”,比氰化钾、*霜砒**的毒性都强!
肉毒杆菌喜欢藏身在肉类、豆类等蛋白质含量高的食物中,在咸味食品中也能存活很长一段时间。
所以,炸酱、豆瓣酱、腐乳、牛肉酱等都比较容易滋生肉毒杆菌,尤其是自制酱料。

凉拌木耳是很多人在夏天特别喜爱的一道菜。但木耳泡发不当,可能滋生“肝衰菌”。
它所产生的毒素会损害肝脏,时间长了还会损害肾脏和大脑。一旦误食,可能出现腹泻、休克,甚至致死,并且致死率相当高。
更可怕的是,“肝衰菌”产生的米酵菌酸目前还没有解药,即便短时间加热煮熟,也不能完全去除。
《BTV我是大医生》节目组对泡发2小时、6小时、12小时的木耳做了一个“肝衰菌”培养实验,结果发现:

此外,发酵的米面食品、淀粉食品,比如凉粉、糯米粉做的食品,如果放置时间过长,也易被“肝衰菌”污染。银耳、腐竹、海参、豆子等食材也建议冷藏泡发。

天气转热,绿豆汤即将登场,但其中可能暗藏“溃疡菌”——金黄色葡萄球菌。它产生的肠毒素A需要煮30分钟才能被消灭,否则进入肠道后会引起黏膜感染、溃疡。
在所有的食物中毒案件中,因它中毒的约占1/3。
绿豆汤在室温下静置5小时,就会开始滋生金黄色葡萄球菌细菌。但在冰箱中,可能放十多天才会滋生大量金黄色葡萄球菌,引起细菌性食物中毒。

最后,小编还要提醒大家:微波炉若不勤清理,也可能成为细菌的“大本营”。

另外,金属、带包装、有膜、密封的东西都不适宜用微波炉加热,以免影响热气散发,造成事故。

健康要身体力行
仔细阅读完后
你会先清理冰箱还是微波炉?